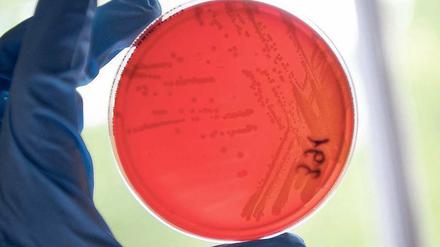

Der beste Schutz vor EHEC-Keimen ist: Grundregeln der Lebensmittelhygiene beachten. Darauf verweisen die Bundeszentrale für gesundheitliche Aufklärung und das Bundesinstitut für Risikobewertung.
Alle Artikel in „Wissen“ vom 25.05.2011

In Dörfern und Städten werden die meisten Singvögel ein Opfer der Hauskatzen

Internet-Pionier erhält Preis in Potsdam
Entscheidungen zwischen Gen und Gefühl

Das Robert Koch-Institut warnt wegen des aggressiven EHEC-Darmkeims vor dem Verzehr von Salatgurken, Blattsalaten und rohen Tomaten insbesondere in Norddeutschland.

Die Berliner Hochschulen sind heiß begehrt, der Numerus Clausus in vielen Fächern hoch. Doch mit geschickten Strategien können es Schulabgänger schaffen, zum gewünschten Studienplatz zu kommen.

Die Freie Universität könnte bedrohte Forschungsstelle aus Kiel übernehmen
Die Humboldt-Universität und die Freie Universität bekommen jeweils einen Sonderforschungsbereich (SFB) von der Deutschen Forschungsgemeinschaft (DFG). Damit verfügen beide Unis jetzt über jeweils sieben SFB (ohne Medizin).

Nach dem EHEC-Ausbruch arbeiten die Forscher unter Hochdruck. "E.coli O104" soll Ursache der Infektionen sein - ein sehr seltener Erreger. Nun gibt das Robert-Koch-Institut eine erste Warnung heraus.
Von Tür zu Tür: Wie Seuchenexperten versuchen, die Quelle der EHEC-Infektion ausfindig zu machen. Einen ersten Hinweis gibt es in Frankfurt am Main.
Spätestens zum 1. Juni haben üblicherweise alle Hochschulen ihre Online-Portale für Bewerbungen in NC-Fächern freigeschaltet – so auch in Berlin die FU und die TU.
Es kann lebensbedrohlich sein. Das Darmbakterium EHEC breitet sich in Norddeutschland rasant aus. Wie ernst ist die Lage?